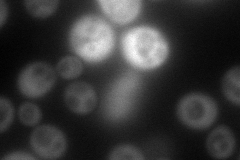
YKR084C
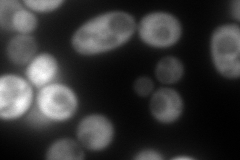
YKR084C
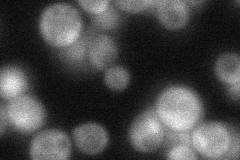
YKR084C
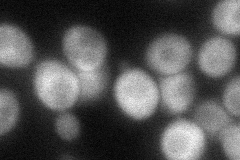
YKR084C

View description
GTP binding protein with sequence similarity to the elongation factor class of G proteins, EF-1alpha and Sup35p; associates with Dom34p, and shares a similar genetic relationship with genes that encode ribosomal protein components
Localization:
Intensity:
Fold change:
Significance:
-
C’ GFP library in SD

below threshold15.62 -
N' NOP1pr-GFP in SD
cytosol127.828 -
N' TEF2pr-mCherry in SD
cytosol313.868 -
N' NATIVEpr-GFP in SD
cytosol37.6487 -
N' TEF2pr-VC and Cyto-VN in SD
cytosol63.8729 -
C’ GFP library in SD+DTT

cytosol16.321.04No -
C’ GFP library in SD+H2O2

cytosol17.31.1No -
C’ GFP library in Starvation Media

cytosol14.430.92No -
C’ GFP library on the background of Pup2-DaMP

below threshold -
C’ GFP library on the background of CCT mutant

below threshold18.46391.18109No
